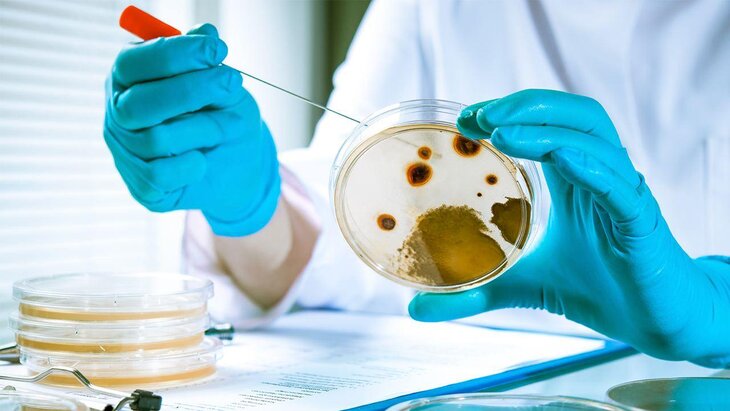

Путин подписал закон об уголовной ответственности за провоз патогенов в РФ
Фото: depositphotos/alexraths
Владимир Путин подписал закон об уголовной ответственности за провоз патогенных материалов на территорию России. Документ опубликован на сайте официального опубликования правовых актов.
Так, законом вводится уголовная ответственность за перемещение опасных вирусов и патогенов через государственную границу вплоть до 12 лет лишения свободы со штрафом до двух миллионов рублей. Помимо этого, за нарушение правил безопасности при обращении с патогенами предлагается повысить ответственность до 8 лет лишения свободы.
Документ был разработан по итогам расследования деятельности американских биолабораторий на территории Украины. Авторами инициативы выступила группа депутатов Госдумы, в том числе глава комитета по безопасности Василий Пискарев, вице-спикер Госдумы Ирина Яровая, глава комитета по обороне Андрей Картаполов и другие.
Ранее глава Роспотребнадзора Анна Попова заявила, что некоторые государства реализуют под видом сотрудничества военно-биологические программы, в рамках которых создаются объекты, несущие угрозу для третьих стран. Она отметила, что Россия на протяжении многих лет выступает с заявлениями о существовании угрозы, исходящей от создания США биологических объектов по периметру российской территории.
Между тем Россия не создает химической угрозы для Украины, подчеркнул постоянный представитель РФ при Организации по запрещению химоружия, посол страны в Гааге Владимир Тарабрин. Он также отметил, что многие иностранные эксперты указывают на использование военными Украины химического оружия.
Пентагон обладает сетью биолабораторий с вариантами вирусных патогенов – МО РФ